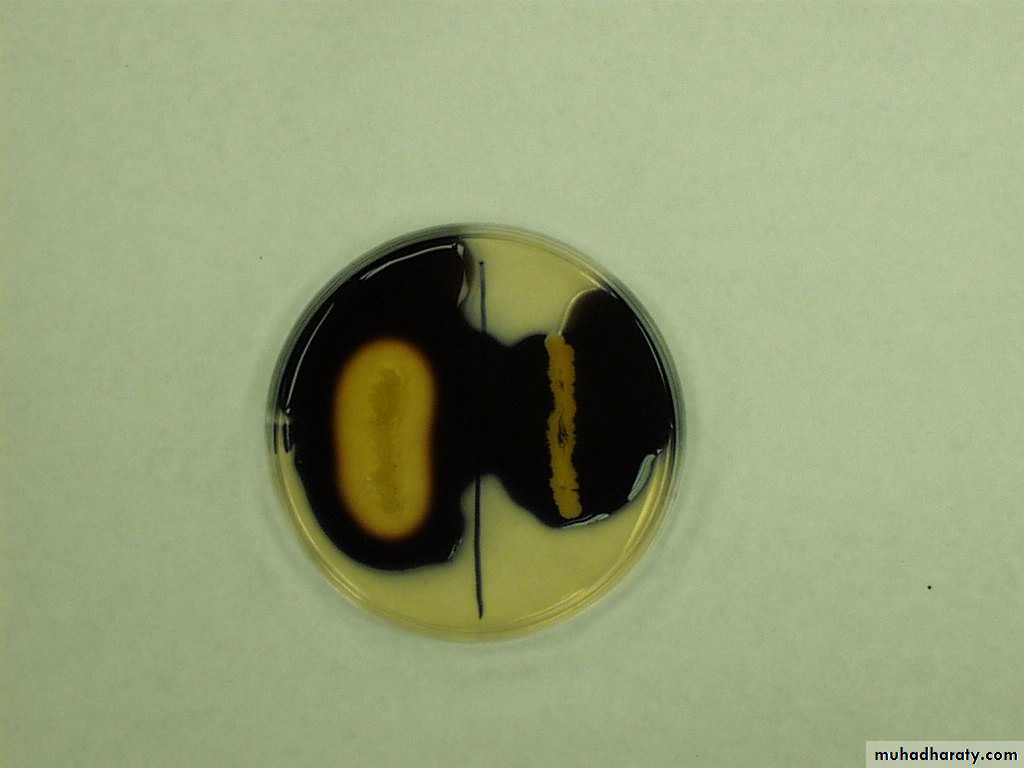

Lab 5
PurposeThis test use to
1- detect organisims that ferment different types of sugars
2- detect the bacteria that degrade amino acid and produce H₂S gas (H₂S gas will react with Fe and produce black precipitate between the slant and butt).
FeSO4 + H2S → FeS↓ + H2SO4
(Black ppt.)
The media used in this test contain
1- three sugars (glucose, lactose .sucrose)
2- pepton (protein has amino acid and sulfur)
3 –phenol red (as indicator sugar fermentation)
A as source of iron and sulfur) ) 4- FeSO4
TSI test (triple sugar iron agar)
procedureInoculate the slants with a pure culture by streaking over the entire surface of the slant (zig-zag to cover surface)and then stabbing deep into the butt.
Incubate at 37ºC for 24 hours .
Result s :
1-If there is no fermentation = red color
• 2-If bacteria ferment lactose and sucrose = yellow slant
• 3-If bacteria ferment glucose = yellow butt
• 4-If bacteria produce gas from fermentation = cracks in the butt.
black preciptate =5- Also If bacteria produce H₂S
Salmonella typhi
-/+/+Shigella
Salmonella typhimurium
E.Coli
Pseudomonas
Proteus vulgaris
Sugar fermentation test
Purpose
To determine if a bacterium can ferment a particular carbohydrate and determine the end products of that fermentation .
Media ingredients:
0.5%-1.0% of the carbohyrate to be tested ( use: lactose, glucose , sucrose, dulcitol, saccharose, sorbitol, and mannitol), nutrient broth, and the pH indicator phenol red(red at pH 7.4 and yellow below pH 6.8).
procedure
The test organism is inoculated into a broth containing the test sugar and incubated for 3 days at 37C°.Result s :
• 1-If there is no fermentation = remain Red color(-ve)
2-If there is fermentation = yellow color (+ve)
3-If there is fermentation and gas prduction = yellow color and displacement of medium from the Durham tube (+ve)with gas .
• ـ
• Carbohydrate Fermentation tubes• (+)ve (+) with (-)ve
Purpose
Some bacteria are capable of using starch as a source of carbohydrate, but in order to do this, they must first hydrolyze or break down the starch so it may enter the cell. The bacterium secretes an exoenzyme, which hydrolyzes the starch by breaking the bonds between the glucose molecules.procedure
Make a single streak line, with the organism on the starch agar plate.
Incubate at 37°C until the next lab period.
Starch Hydrolysistest
Results
Iodine will be added to the plate. Iodine reacts with starch to produce a dark brown or blue/black color.• + ve =If starch has been hydrolyzed, there will be a clear zone around the bacterial growth.(Left side)
- ve = If starch has not been hydrolyzed, the agar will remain a dark brown or blue/black color .(Right side)
Principle
It is used to determine if an organism is capable of reducing nitrate (NO3-) to nitrite (NO2-) or other nitrogenous compounds via the action of the enzymenitratase (also called nitrate reductase).
NO3– NO2–
Purpose
All enterobacteriacae give(+ve) result , so by this test can differentiate enterobacteriacae from G-ve non- enteric bacteria .
procedure
The test organism is inoculated into nitrate tubes containing the nitrate broth and incubated at 37ºC for 24 hour .Nitrate Reduction Test
Results After addition of specific reagents.and has no gas 1-Tube 1 is (-) it did not turn red2- tube 2 is (+) because it is red indicating presence of nitrite,3- tube 3 is also (+) while there is no red color to indicate the presence of nitrite there is nitrogen gas
1
2
3
Oxidase Test
PrincipleThis test is used to identify microorganisms containing the enzyme cytochrome oxidase (important in the electron transport chain).
Purpose
It is commonly used to
1- distinguish between oxidase negative (-ve) Enterobacteriaceae and oxidase positive(+ve) Pseudomonas and Neisserria.
2- differentiate Neisserria and G⁺ve cocci
procedure
Transfer loopful of test organism to the filter paper saturated with (tetramethyl-p-phenylene diamine dihydrochloride) reagent .
Result s :
When the electron donor(T.P.d.d) is oxidized by cytochrome oxidase it turns a dark purple. This is considered a positive result. In the picture below the organism on the right (Pseudomonas aeruginosa) is oxidase positive.
Gelatin Hydrolysis Test
PrincipleThe ability of microorganisms to hydrolyze gelatin Some bacteria produce a proteolytic enzyme called gelatinase, that hydrolyzes gelatin .
Purpose
Most of the Enterobacteriaceae are gelatin-hydrolysis-test negative. Bacteria like Vibrio, Bacillus, and Pseudomonas are gelatin-positive.
Procedure
Inoculated nutrient gelatin media(first tube) with test organisms and let the second tube without inoculation as a control.
Tubes are incubated for at least 48 hrs and then placed into the refrigerator for approximately 30 minutes.
Results
+ = refrigerated gelatin remains liquid (at least partially)- = the gelatin is still intact , refrigerated gelatin is solid.